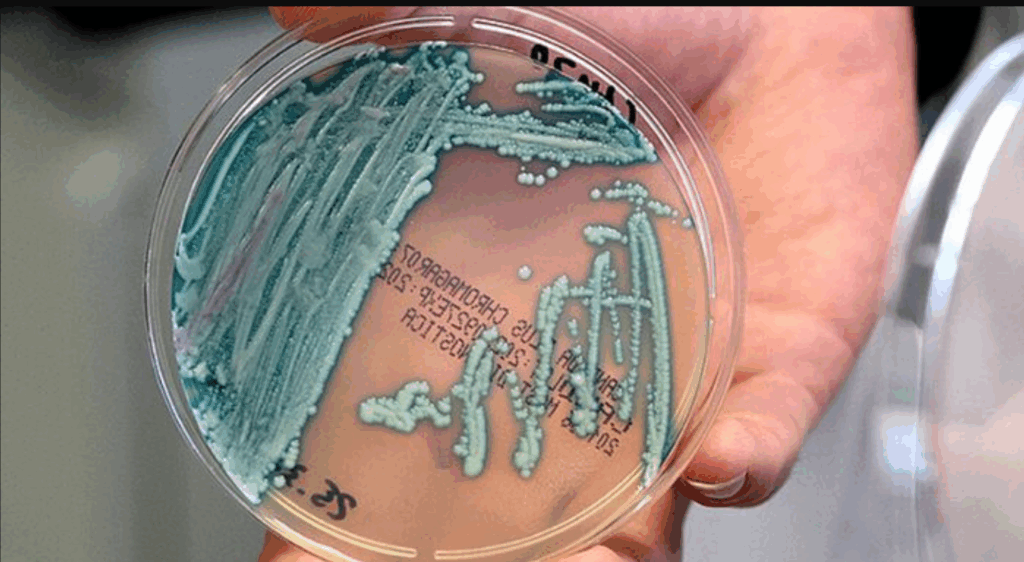

Pentru a vă oferi cele mai bune experiențe, folosim tehnologii precum cookie-urile pentru a stoca și/sau accesa informații despre dispozitiv. Acordarea consimțământului pentru aceste tehnologii ne va permite să procesăm date precum comportamentul de navigare sau identificatorii unici de pe acest site. Neacordarea consimțământului sau retragerea acestuia poate afecta negativ anumite funcționalități și caracteristici
The technical storage or access is strictly necessary for the legitimate purpose of enabling the use of a specific service explicitly requested by the subscriber or user, or for the sole purpose of carrying out the transmission of a communication over an electronic communications network.
The technical storage or access is necessary for the legitimate purpose of storing preferences that are not requested by the subscriber or user.
The technical storage or access that is used exclusively for statistical purposes.
The technical storage or access that is used exclusively for anonymous statistical purposes. Without a subpoena, voluntary compliance on the part of your Internet Service Provider, or additional records from a third party, information stored or retrieved for this purpose alone cannot usually be used to identify you.
The technical storage or access is required to create user profiles to send advertising, or to track the user on a website or across several websites for similar marketing purposes.